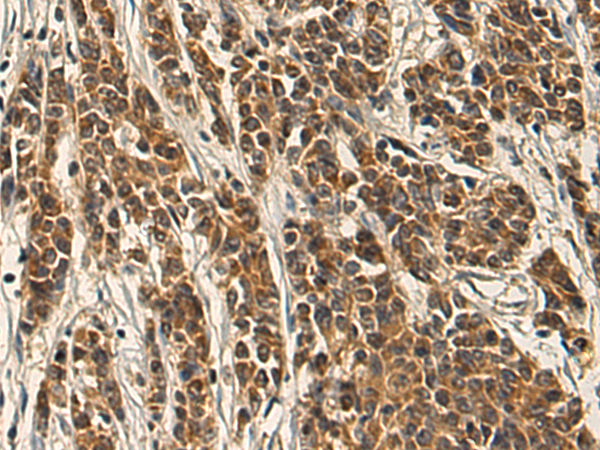
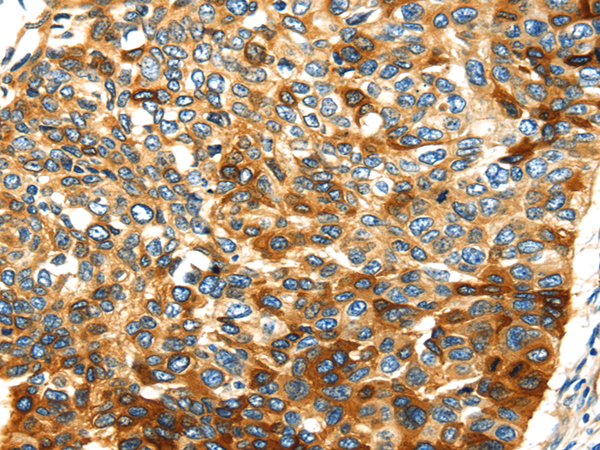
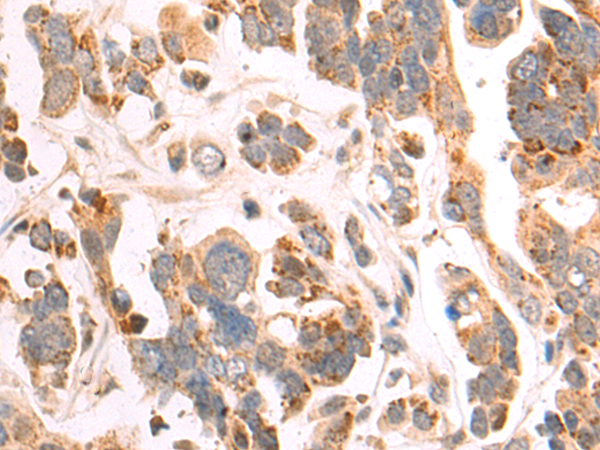

-
分类: 科研抗体货号: P08789别名: CEDNIK; SNAP-29应用: IHC反应种属: Human, Mouse, Rat
-
分类: 科研抗体货号: P08790别名: SVAP1; HEL170; SNAP-47; C1orf142; ESFI5812; HEL-S-290应用: IHC反应种属: Human
-
分类: 科研抗体货号: P08806别名: SSA; RO52; SSA1; RNF81; Ro/SSA应用: WB反应种属: Human
-
分类: 科研抗体货号: P08787别名: SMUC; SNAIL3; ZNF293; Zfp293应用: IHC反应种属: Human
-
分类: 科研抗体货号: P08805别名: PPG; PRG; PRG1应用: IHC反应种属: Human
-
分类: 科研抗体货号: P08786别名: ZMYND21应用: IHC反应种属: Human
-
分类: 科研抗体货号: P08804别名: WRP; MEGAP; SRGAP2; ARHGAP14应用: IHC反应种属: Human, Mouse
-
分类: 科研抗体货号: P08785别名: KMT3E; ZMYND1; ZNFN3A1; bA74P14.1应用: WB,IHC反应种属: Human, Mouse
-
分类: 科研抗体货号: P08803别名: spry-3应用: WB,IHC反应种属: Human, Mouse
-
分类: 科研抗体货号: P08782别名: SM22; SMCC; TAGLN1; WS3-10应用: IHC反应种属: Human, Rat

鄂公网安备42018502007531号
鄂公网安备42018502007531号

